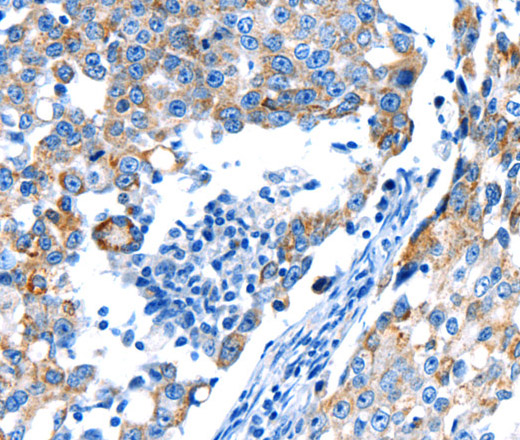
Валидация Elabscience E-AB-12576

| UNIPROT | P01189 |
| Иммуноген | Синтетический пептид, соответствующий человеческому POMC |
POMC Polyclonal Antibody (E-AB-12576)
Реактивность подтвержденная:
человек, мышь
Источник (хозяин):
кролик
Валидировано для:
IHC
WB
Характеристики
Публикации
Техническое описание
| Каталожный номер | E-AB-12576 |
| Название антигена | Proopiomelanocortin (POMC) |
| UNIPROT | P01189 |
| Иммуноген | Синтетический пептид, соответствующий человеческому POMC |
| Английские синонимы | POC, NPP, ProOMC, ACTH, Pro-OMC, Pro Opiomelanocortin, Corticotropin-lipotropin, Corticotropin, Adrenocorticotropic hormone |
| Русские синонимы | ПОМК, кортикотропин-подобный иммунный пептид |
Реактивность подтвержденная Нужна другая реактивность? |
человек, мышь |
| Источник (хозяин) | кролик |
| Изотип | IgG |
| Клональность | поликлональное |
| Рекомбинантное | нет |
| Готовое к использованию | нет |
| Концентрация | 0.3 мг/мл |
| Конъюгат | нет |
| Валидировано для | IHC WB Иммуногистохимия; Вестерн-блоттинг |
| Рекомендуемые разведения | WB 1:1000-1:5000; IHC 1:25-1:100 |
| Метод очистки | Аффинная хроматография |
| Состав буфера | PBS с 0.05% азид натрия и 50% глицерин, PH7.4 |
| RRID | AB_532717 |
| Условия доставки | термобокс с аккумуляторами холода |
| Условия хранения | Хранить при -20°C - 12 месяцев. Избегать повторяющихся циклов замораживания/оттаивания |
| Срок хранения | 12 месяцев |
| Производитель | Elabscience |
| Ссылка на страницу товара на сайте производителя | https://www.elabscience.com/p-pomc_polyclonal_antibody-e_ab_12576 |
|
Артикул
|
Наименование |
Производитель
|
|---|
|
Артикул
|
Наименование |
Производитель
|
|---|
|
Артикул
|
Наименование |
Производитель
|
|---|
|
Артикул
|
Наименование |
Производитель
|
|---|
|
Артикул
|
Наименование |
Производитель
|
|---|
|
Артикул
|
Наименование |
Производитель
|
|---|
|
Артикул
|
Наименование |
Производитель
|
|---|
Акции и предложения
Популярные продукты:
SENP2 Antibody (AF6534)
Источник (хозяин): кролик
Реактивность подтвержденная: человек
Реактивность подтвержденная: человек
Monoclonal Antibody to Complement Component 5a (C5a) (MAA388Hu28)
Источник (хозяин): мышь
Реактивность подтвержденная: человек
Валидировано для: WB
Реактивность подтвержденная: человек
Валидировано для: WB
Monoclonal Antibody to Complement Component 5a (C5a) (MAA388Mu22)
Источник (хозяин): мышь
Реактивность подтвержденная: мышь
Валидировано для: ICC, IF
Реактивность подтвержденная: мышь
Валидировано для: ICC, IF
Mini Samples ELISA Kit for Alkaline Phosphatase (ALP) (MEB472Hu)
Организм: человек
Диапазон определения: 1.56-100 нг/мл
Чувствительность: 0.055 нг/мл
Диапазон определения: 1.56-100 нг/мл
Чувствительность: 0.055 нг/мл
Mouse Thyrotropin subunit β(TSHB) ELISA kit (E03T0738)
Организм: мышь
Human Thyrotropin subunit β(TSHB) ELISA kit (E01T0738)
Организм: человек
Диапазон определения: 5-100 мл Ед/мл
Чувствительность: 1 мл Ед/мл
Диапазон определения: 5-100 мл Ед/мл
Чувствительность: 1 мл Ед/мл